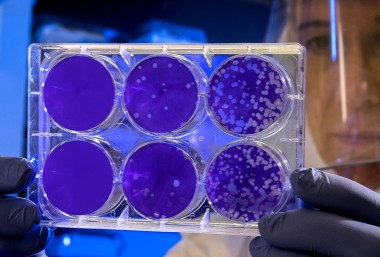

UPDATED 8 DECEMBER 2021
Operating in the traffic light system
New Zealand moved to the government’s Covid-19 protection framework at 11.59pm on 2 December. This new traffic light system sets out to manage Covid in the community and minimise its spread. You can find out more on the Covid-19 website here.
It’s important to note that AJ Park will remain a vaccinated workplace in all levels. Here is some guidance on how we will operate in the Covid-19 traffic light system:
Red light
- The office will be closed to external parties
Orange light
- The office will be open for client meetings and external functions with health and safety considerations
- Record keeping and scanning is required
- Face coverings and 1m distancing are mandatory in the office
- If you are travelling from another region, we ask you disclose this
Green light
- The office will be open for client meetings and external functions
- Record keeping and scanning is required
- Face coverings are encouraged
UPDATED 13 SEPTEMBER 2021
Given the ongoing emergence of ‘mystery’ cases the government has decided to keep Auckland in alert level 4 restrictions for one more week, until 11.59pm on Tuesday 21 September. Cabinet has also decided that Wellington (and the rest of the country outside of Auckland) will remain in alert level 2 until at least 21 September.
As a reminder, we continue to be available to provide services to potential and existing clients, however both of our offices remain closed at these alert levels.
UPDATED 30 AUGUST 2021
The government announcement today that the Auckland region will remain in alert level 4 until 11.59pm on Tuesday 14 September. The Wellington region will move to alert level 3 from 11.59pm on Tuesday 31 August. It is heartening to see the lower number of positive cases today and we hope this is the start of a trend that means restrictions can be eased as soon as it's possible.
As a firm, we remain extra cautious of the contagious Delta variant. To protect our people and clients, both our Wellington and Auckland offices will remain closed during alert levels 3/4 and our people will continue working remotely. We remain committed to delivering high-quality services to our clients through this unsettling time.
UPDATED 23 AUGUST 2021
While the government gathers more information about the current outbreak of the Delta variant, Auckland will remain under alert level 4 restrictions until 11.59pm on Tuesday 31 August. The rest of New Zealand will be in alert level 4 until 11.59pm on Friday 27 August. So, we’ll continue working under level 4 restrictions in line with Government timeframes.
UPDATED 18 AUGUST 2021
Yesterday, the New Zealand government announced that there was case of COVID-19 Delta in the community.
New Zealand has moved into alert level 4. These restrictions will be in place until 11.59pm on Friday 20 August for the Wellington region and until 11:59pm on Tuesday 24 August for the Auckland region. This may be subject to change and we will update this page as the situation unfolds.
The level 4 alert means that all AJ Park staff must work from home but will continue to provide our clients with the high-quality services that they know and expect. All client meetings will be held virtually, and our people are contactable via the same phone numbers and email addresses. You can read more about our COVID-19 response plan below.
This is an unprecedented time, and we would like to assure you of our preparedness and our commitment to minimising disruption to our services. If you need more information or clarification on any of the above or below points, please don’t hesitate to contact our managing director, Dr Andrea Dickens.
UPDATED 12 MARCH 2021
Auckland joined the rest of New Zealand at alert level 1 at midday on Friday 12 March. This means the disease is contained in New Zealand.
At alert level 1, everyone can return without restriction to work, school, and domestic travel. There are also no restrictions on the number of people who can get together for gatherings, meetings, events etc.
All AJ Park staff are now back to their normal working arrangements and we look forward to resuming face-to-face meetings with our local clients and suppliers. Strict hygiene, social distancing and contact tracing measures are in place for anyone who visits our Auckland and Wellington offices.
UPDATED 8 MARCH 2021
The Auckland region is currently at alert level 2 and the rest of the country is at alert level 1. These alert levels came into effect at 6.00am on Sunday 7 March.
AJ Park’s Auckland office
Our Auckland office staff are currently working remotely all client meetings will be held virtually.
AJ Park’s Wellington office
Our Wellington staff are back to normal working arrangements in the office. We have also resumed face-to-face meetings with local clients and suppliers. Strict hygiene, social distancing and contact tracing measures are in place for anyone who visits our Wellington office. We can also visit our clients on site, if permitted under their protocols.
If you have any questions about our COVID-19 response plan or our services under alert level 2 or alert level 1, please don't hesitate to contact us.
UPDATED 14 FEBRUARY 2021
Due to a recent outbreak of COVID-19 in Auckland, the Auckland region will move to alert level 3 and the rest of the country will move to alert level 2 from midnight tonight. These restrictions will be in place until 11.59pm on Wednesday 16 February 2021. During this short lockdown period, all staff in both our Auckland and Wellington offices will be working remotely. We are taking this measure to help protect the health and wellbeing of our people, our clients and our communities. While working remotely, our people will continue to provide you with the high-quality services that you know and expect. You can still contact your usual firm contacts using the same phone numbers and same email addresses, however, all client meetings will be held virtually.
If you have any questions about our COVID-19 response plan or our services under the current alert levels, please do not hesitate to contact me or any of the individuals listed below.
UPDATED 8 OCTOBER 2020
Auckland joined the rest of New Zealand at alert level 1 on Thursday 8 October. This means the disease is contained in New Zealand.
At alert level 1, everyone can return without restriction to work, school, and domestic travel. There are also no restrictions on the number of people who can get together for gatherings, meetings, events etc.
All AJ Park staff are now back to their normal working arrangements and we look forward to resuming face-to-face meetings with our local clients and suppliers. Strict hygiene, social distancing and contact tracing measures are in place for anyone who visits our Auckland and Wellington offices.
UPDATED 23 SEPTEMBER 2020
The majority of New Zealand has eased back to COVID-19 alert level 1, however, Auckland remains in alert level 2.
Our Wellington staff are back to normal working arrangements in the office. We have also resumed face-to-face meetings with local clients and suppliers.
Our Auckland office is operating a team A and B protocol. Team A is working in the office, and team B is working remotely. While client meetings can still be held in person, our preference is to meet with you over the phone or via video conference.
Strict hygiene, social distancing and contact tracing measures are in place for anyone who visits our Auckland and Wellington offices. We can also visit clients on site, if permitted under their protocols.
If you have any questions about our COVID-19 response plan or our services under alert level 2 or alert level 1, please don't hesitate to contact us
UPDATED 31 AUGUST 2020
New Zealand is currently in alert level 2. We are therefore operating a team A and B protocol. Team A is working in the office, and team B is working remotely.
While client meetings can still be held in person, our preference is to meet with you over the phone or via video conference. Strict hygiene, social distancing and contact tracing measures are in place for anyone who visits our Auckland or Wellington offices. We can also visit clients on site, if permitted under their protocols.
If you have any questions about our COVID-19 response plan or our services under alert level 2, please don't hesitate to contact one of our response team members below.
Updated 12 August 2020
Unfortunately, after more than 100 days of no community transmission of COVID-19 in New Zealand, the country’s alert levels changed at midday today. The Auckland region has moved to alert level 3 and all of our Auckland office staff are now required to work remotely. The rest of the country has moved to alert level 2. Our Wellington office will be operating a team A and B protocol. Team A is working in the office, and team B is working from home. While client meetings can still be held in person in our Wellington office, our preference is to meet with you over the phone or via video conference. Strict hygiene, social distancing and contact tracing measures are in place for anyone who visits our Wellington office.
If you have any questions about our COVID-19 response plan or our services under the current alert levels, please do not hesitate to contact me or any of the individuals listed below.
Updated 11 June 2020
New Zealand moved to alert level 1 at 11:59pm on Monday 8 June. This means the disease is contained in New Zealand.
At alert level 1, everyone can return without restriction to work, school, and domestic travel. There are also no restrictions on the number of people who can get together for gatherings, meetings, events etc.
AJ Park will be transitioning staff back into the office from Tuesday 9 June. From Monday 6 July, we are expecting everyone will be back to their normal working arrangements.
We look forward to resuming face to face meetings with local clients and suppliers.
Updated 29 May 2020
New Zealand moved to alert level 2 at 11:59pm on Wednesday 13 May. This means all businesses can open to customers if they can do it safely.
AJ Park have been operating a team A and B protocol since Monday 18 May. Team A are working in the office, and team B are working from home. At alert level 2, client meetings can be held in person at our offices. However, our preference is to continue to meet with our clients over the phone or via video conference as strict hygiene, social distancing and contact tracing measures will be put in place for anyone who visits our offices. We can also visit clients on site, if permitted under their protocols.
If you have any questions about our COVID-19 response plan or our services under alert level 2, please don't hesitate to contact me or one of our response team members below.
Updated 4:20pm, 23 March 2020
The Prime Minister today, confirmed that the country has moved to COVID-19 level 3, and will move to level 4 from midnight Wednesday, for at least four weeks. The level 4 alert means that all AJ Park staff must work remotely from midnight Wednesday.
With the escalation of the COVID-19 pandemic globally and in line with the New Zealand Government’s advice to implement alternative work arrangements to help slow the spread of the virus in the community, AJ Park has made the decision to move our people to remote working, effective immediately.
While we are taking this measure to help protect the health and well-being of our people, our clients and our communities, we don’t anticipate any changes to the services you receive.
AJ Park has a comprehensive COVID-19 response plan and procedures in place, and we are committed to maintaining the high-quality services that you know and expect from us:
- Our priority is to ensure the health and wellbeing of our employees and see to it that any operational changes will not impact client services.
- While working remotely, our people will continue to provide you with the high-quality services that you know and expect.
- We have robust IT systems, which have been tested and can sustain a remote workforce.
- You can still contact your usual firm contacts using the same phone numbers and same email address.
- All client meetings will be held virtually.
- Please avoid sending us courier packages or hard copy documents unless necessary.
- Our team is monitoring advice from IPONZ and IP Australia, and other IP offices, and will advise of any changes that may impact you.
The implementation of our remote working protocol is in addition to the following proactive steps we have already taken as part of our COVID-19 response plan:
- We continue to monitor guidance and advice from relevant government bodies and their medical experts and update our business response plan and procedures as required.
- We have activated our internal COVID-19 policies and procedures and will continue to monitor circumstances and update our policies and procedures accordingly and promptly.
- We have had travel restrictions in place since mid-February and these are continuously updated in line with Government advice.
This is an unprecedented time and we would like to assure you of our preparedness and our commitment to minimising disruption to our services. If you need more information or clarification on any of the above points, please don’t hesitate to contact me or one of our response team members below.
UPDATED 8 DECEMBER 2021
Operating in the traffic light system
New Zealand moved to the government’s Covid-19 protection framework at 11.59pm on 2 December. This new traffic light system sets out to manage Covid in the community and minimise its spread. You can find out more on the Covid-19 website here.
It’s important to note that AJ Park will remain a vaccinated workplace in all levels. Here is some guidance on how we will operate in the Covid-19 traffic light system:
Red light
- The office will be closed to external parties
Orange light
- The office will be open for client meetings and external functions with health and safety considerations
- Record keeping and scanning is required
- Face coverings and 1m distancing are mandatory in the office
- If you are travelling from another region, we ask you disclose this
Green light
- The office will be open for client meetings and external functions
- Record keeping and scanning is required
- Face coverings are encouraged
UPDATED 13 SEPTEMBER 2021
Given the ongoing emergence of ‘mystery’ cases the government has decided to keep Auckland in alert level 4 restrictions for one more week, until 11.59pm on Tuesday 21 September. Cabinet has also decided that Wellington (and the rest of the country outside of Auckland) will remain in alert level 2 until at least 21 September.
As a reminder, we continue to be available to provide services to potential and existing clients, however both of our offices remain closed at these alert levels.
UPDATED 30 AUGUST 2021
The government announcement today that the Auckland region will remain in alert level 4 until 11.59pm on Tuesday 14 September. The Wellington region will move to alert level 3 from 11.59pm on Tuesday 31 August. It is heartening to see the lower number of positive cases today and we hope this is the start of a trend that means restrictions can be eased as soon as it's possible.
As a firm, we remain extra cautious of the contagious Delta variant. To protect our people and clients, both our Wellington and Auckland offices will remain closed during alert levels 3/4 and our people will continue working remotely. We remain committed to delivering high-quality services to our clients through this unsettling time.
UPDATED 23 AUGUST 2021
While the government gathers more information about the current outbreak of the Delta variant, Auckland will remain under alert level 4 restrictions until 11.59pm on Tuesday 31 August. The rest of New Zealand will be in alert level 4 until 11.59pm on Friday 27 August. So, we’ll continue working under level 4 restrictions in line with Government timeframes.
UPDATED 18 AUGUST 2021
Yesterday, the New Zealand government announced that there was case of COVID-19 Delta in the community.
New Zealand has moved into alert level 4. These restrictions will be in place until 11.59pm on Friday 20 August for the Wellington region and until 11:59pm on Tuesday 24 August for the Auckland region. This may be subject to change and we will update this page as the situation unfolds.
The level 4 alert means that all AJ Park staff must work from home but will continue to provide our clients with the high-quality services that they know and expect. All client meetings will be held virtually, and our people are contactable via the same phone numbers and email addresses. You can read more about our COVID-19 response plan below.
This is an unprecedented time, and we would like to assure you of our preparedness and our commitment to minimising disruption to our services. If you need more information or clarification on any of the above or below points, please don’t hesitate to contact our managing director, Dr Andrea Dickens.
UPDATED 12 MARCH 2021
Auckland joined the rest of New Zealand at alert level 1 at midday on Friday 12 March. This means the disease is contained in New Zealand.
At alert level 1, everyone can return without restriction to work, school, and domestic travel. There are also no restrictions on the number of people who can get together for gatherings, meetings, events etc.
All AJ Park staff are now back to their normal working arrangements and we look forward to resuming face-to-face meetings with our local clients and suppliers. Strict hygiene, social distancing and contact tracing measures are in place for anyone who visits our Auckland and Wellington offices.
UPDATED 8 MARCH 2021
The Auckland region is currently at alert level 2 and the rest of the country is at alert level 1. These alert levels came into effect at 6.00am on Sunday 7 March.
AJ Park’s Auckland office
Our Auckland office staff are currently working remotely all client meetings will be held virtually.
AJ Park’s Wellington office
Our Wellington staff are back to normal working arrangements in the office. We have also resumed face-to-face meetings with local clients and suppliers. Strict hygiene, social distancing and contact tracing measures are in place for anyone who visits our Wellington office. We can also visit our clients on site, if permitted under their protocols.
If you have any questions about our COVID-19 response plan or our services under alert level 2 or alert level 1, please don't hesitate to contact us.
UPDATED 14 FEBRUARY 2021
Due to a recent outbreak of COVID-19 in Auckland, the Auckland region will move to alert level 3 and the rest of the country will move to alert level 2 from midnight tonight. These restrictions will be in place until 11.59pm on Wednesday 16 February 2021. During this short lockdown period, all staff in both our Auckland and Wellington offices will be working remotely. We are taking this measure to help protect the health and wellbeing of our people, our clients and our communities. While working remotely, our people will continue to provide you with the high-quality services that you know and expect. You can still contact your usual firm contacts using the same phone numbers and same email addresses, however, all client meetings will be held virtually.
If you have any questions about our COVID-19 response plan or our services under the current alert levels, please do not hesitate to contact me or any of the individuals listed below.
UPDATED 8 OCTOBER 2020
Auckland joined the rest of New Zealand at alert level 1 on Thursday 8 October. This means the disease is contained in New Zealand.
At alert level 1, everyone can return without restriction to work, school, and domestic travel. There are also no restrictions on the number of people who can get together for gatherings, meetings, events etc.
All AJ Park staff are now back to their normal working arrangements and we look forward to resuming face-to-face meetings with our local clients and suppliers. Strict hygiene, social distancing and contact tracing measures are in place for anyone who visits our Auckland and Wellington offices.
UPDATED 23 SEPTEMBER 2020
The majority of New Zealand has eased back to COVID-19 alert level 1, however, Auckland remains in alert level 2.
Our Wellington staff are back to normal working arrangements in the office. We have also resumed face-to-face meetings with local clients and suppliers.
Our Auckland office is operating a team A and B protocol. Team A is working in the office, and team B is working remotely. While client meetings can still be held in person, our preference is to meet with you over the phone or via video conference.
Strict hygiene, social distancing and contact tracing measures are in place for anyone who visits our Auckland and Wellington offices. We can also visit clients on site, if permitted under their protocols.
If you have any questions about our COVID-19 response plan or our services under alert level 2 or alert level 1, please don't hesitate to contact us
UPDATED 31 AUGUST 2020
New Zealand is currently in alert level 2. We are therefore operating a team A and B protocol. Team A is working in the office, and team B is working remotely.
While client meetings can still be held in person, our preference is to meet with you over the phone or via video conference. Strict hygiene, social distancing and contact tracing measures are in place for anyone who visits our Auckland or Wellington offices. We can also visit clients on site, if permitted under their protocols.
If you have any questions about our COVID-19 response plan or our services under alert level 2, please don't hesitate to contact one of our response team members below.
Updated 12 August 2020
Unfortunately, after more than 100 days of no community transmission of COVID-19 in New Zealand, the country’s alert levels changed at midday today. The Auckland region has moved to alert level 3 and all of our Auckland office staff are now required to work remotely. The rest of the country has moved to alert level 2. Our Wellington office will be operating a team A and B protocol. Team A is working in the office, and team B is working from home. While client meetings can still be held in person in our Wellington office, our preference is to meet with you over the phone or via video conference. Strict hygiene, social distancing and contact tracing measures are in place for anyone who visits our Wellington office.
If you have any questions about our COVID-19 response plan or our services under the current alert levels, please do not hesitate to contact me or any of the individuals listed below.
Updated 11 June 2020
New Zealand moved to alert level 1 at 11:59pm on Monday 8 June. This means the disease is contained in New Zealand.
At alert level 1, everyone can return without restriction to work, school, and domestic travel. There are also no restrictions on the number of people who can get together for gatherings, meetings, events etc.
AJ Park will be transitioning staff back into the office from Tuesday 9 June. From Monday 6 July, we are expecting everyone will be back to their normal working arrangements.
We look forward to resuming face to face meetings with local clients and suppliers.
Updated 29 May 2020
New Zealand moved to alert level 2 at 11:59pm on Wednesday 13 May. This means all businesses can open to customers if they can do it safely.
AJ Park have been operating a team A and B protocol since Monday 18 May. Team A are working in the office, and team B are working from home. At alert level 2, client meetings can be held in person at our offices. However, our preference is to continue to meet with our clients over the phone or via video conference as strict hygiene, social distancing and contact tracing measures will be put in place for anyone who visits our offices. We can also visit clients on site, if permitted under their protocols.
If you have any questions about our COVID-19 response plan or our services under alert level 2, please don't hesitate to contact me or one of our response team members below.
Updated 4:20pm, 23 March 2020
The Prime Minister today, confirmed that the country has moved to COVID-19 level 3, and will move to level 4 from midnight Wednesday, for at least four weeks. The level 4 alert means that all AJ Park staff must work remotely from midnight Wednesday.
With the escalation of the COVID-19 pandemic globally and in line with the New Zealand Government’s advice to implement alternative work arrangements to help slow the spread of the virus in the community, AJ Park has made the decision to move our people to remote working, effective immediately.
While we are taking this measure to help protect the health and well-being of our people, our clients and our communities, we don’t anticipate any changes to the services you receive.
AJ Park has a comprehensive COVID-19 response plan and procedures in place, and we are committed to maintaining the high-quality services that you know and expect from us:
- Our priority is to ensure the health and wellbeing of our employees and see to it that any operational changes will not impact client services.
- While working remotely, our people will continue to provide you with the high-quality services that you know and expect.
- We have robust IT systems, which have been tested and can sustain a remote workforce.
- You can still contact your usual firm contacts using the same phone numbers and same email address.
- All client meetings will be held virtually.
- Please avoid sending us courier packages or hard copy documents unless necessary.
- Our team is monitoring advice from IPONZ and IP Australia, and other IP offices, and will advise of any changes that may impact you.
The implementation of our remote working protocol is in addition to the following proactive steps we have already taken as part of our COVID-19 response plan:
- We continue to monitor guidance and advice from relevant government bodies and their medical experts and update our business response plan and procedures as required.
- We have activated our internal COVID-19 policies and procedures and will continue to monitor circumstances and update our policies and procedures accordingly and promptly.
- We have had travel restrictions in place since mid-February and these are continuously updated in line with Government advice.
This is an unprecedented time and we would like to assure you of our preparedness and our commitment to minimising disruption to our services. If you need more information or clarification on any of the above points, please don’t hesitate to contact me or one of our response team members below.